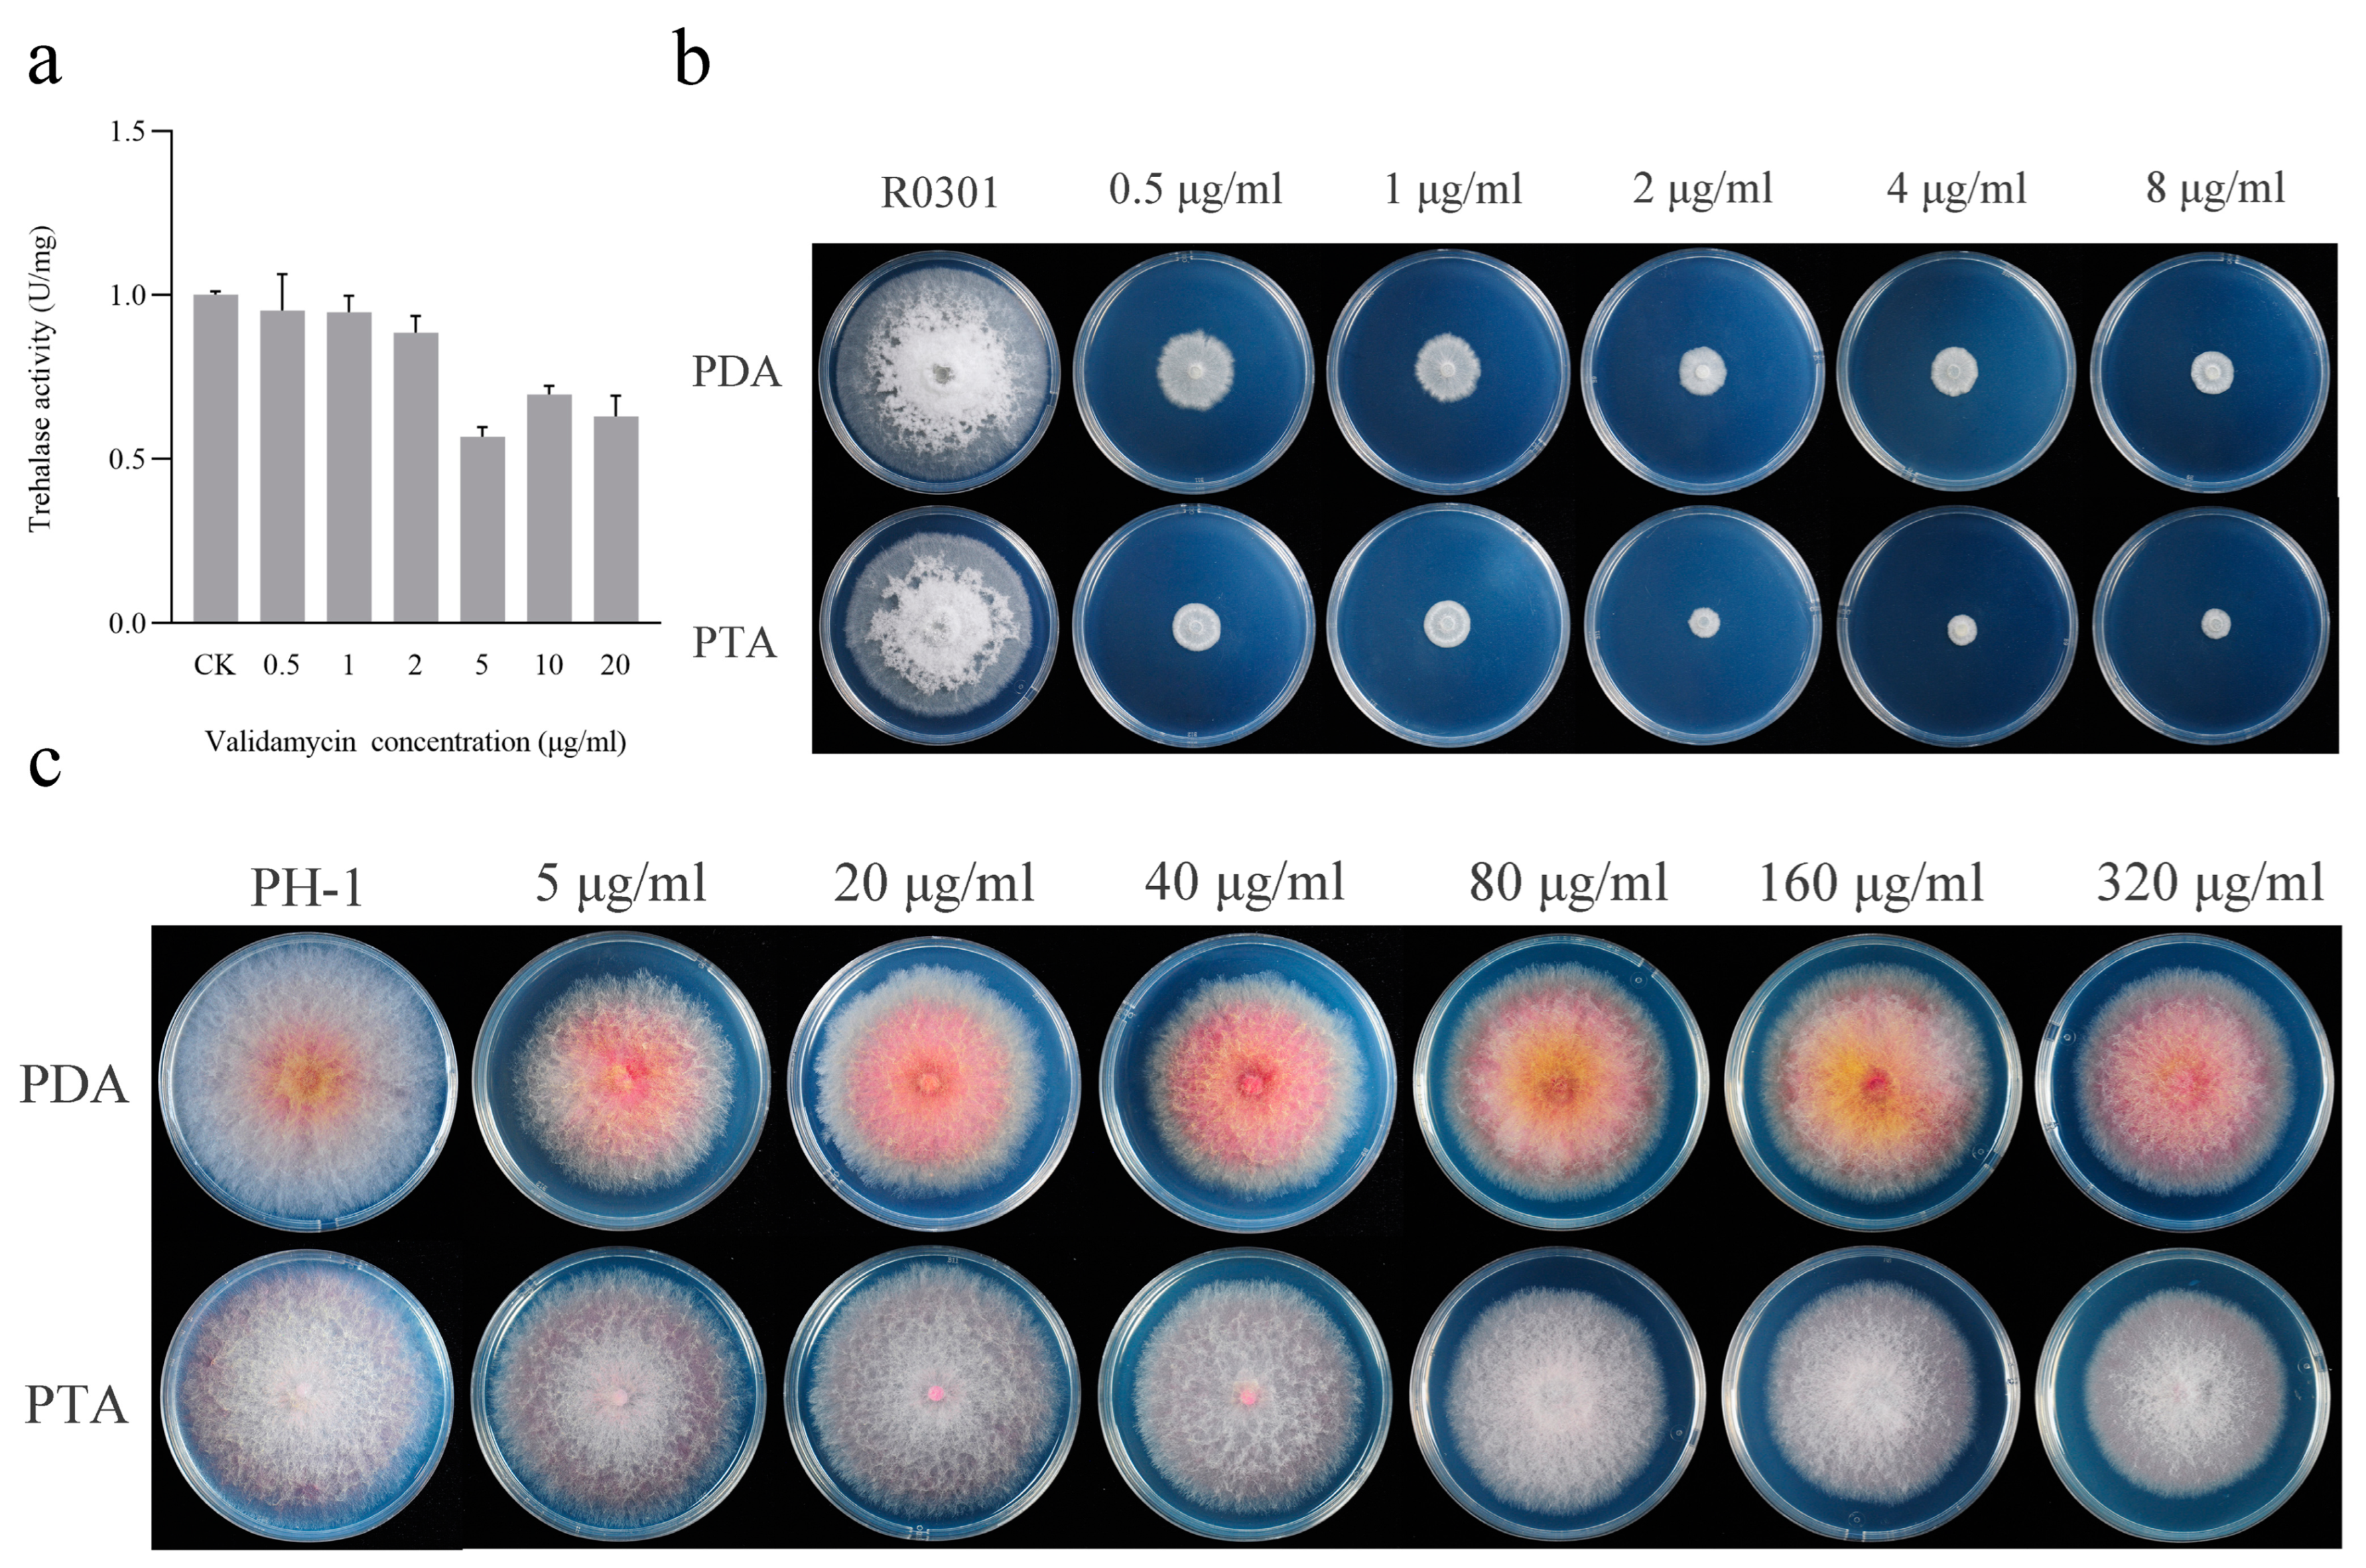
Jof 09 00846 g001 Jof 09 00846 g001

Trehalase Inhibitor Validamycin May Have Additional Mechanisms of Toxicology against Rhizoctonia cerealis
Abstract
1. Introduction
2. Materials and Methods
2.1. Strains, Culture Conditions, and Validamycin A Sensitivity Assay
2.2. Extraction of Trehalase from the Mycelium of R0301
2.3. Determination of Trehalase Activity in Mycelia
2.4. Phylogenetic Analysis of Trehalase Genes in R. cerealis
2.5. RNA Extraction and cDNA Synthesis
2.6. Construction of Transcriptome Libraries and Acquisition of Transcriptome Data
3. Results
3.1. Validamycin Inhibited the Hyphal Growth and Trehalase Activity of R. cerealis
3.2. Trehalase Genes in R. cerealis and Their Expression after Validamycin Treatment
3.3. Integrated Analysis of the Transcriptome of R. cerealis
3.4. KEGG Enrichment Analysis of DEGs
4. Discussion
Author Contributions
Funding
Conflicts of Interest
References
- Hamada, M.S.; Yin, Y.; Chen, H.; Ma, Z. The escalating threat of Rhizoctonia cerealis, the causal agent of sharp eyespot in wheat. Pest Manag. Sci. 2011, 67, 1411–1419. [Google Scholar] [CrossRef] [PubMed]
- Lemańczyk, G.; Kwaśna, H. Effects of sharp eyespot (Rhizoctonia cerealis) on yield and grain quality of winter wheat. Eur. J. Plant Pathol. 2013, 135, 187–200. [Google Scholar] [CrossRef]
- Li, W.; Guo, Y.; Zhang, A.; Chen, H. Genetic structure of populations of the wheat sharp eyespot pathogen Rhizoctonia cerealis anastomosis group D subgroup I in China. Phytopathology 2017, 107, 224–230. [Google Scholar] [CrossRef][Green Version]
- Wu, X.; Wang, J.; Wu, D.; Jiang, W.; Gao, Z.; Li, D.; Wu, R.; Gao, D.; Zhang, Y. Identification of new resistance loci against wheat sharp eyespot through genome-wide association study. Front. Plant Sci. 2022, 13, 1056935. [Google Scholar] [CrossRef] [PubMed]
- Sun, H.Y.; Lu, C.Q.; Li, W.; Deng, Y.Y.; Chen, H.G. Homozygous and heterozygous point mutations in succinate dehydrogenase subunits b, c and d of Rhizoctonia cerealis conferring resistance to thifluzamide. Pest Manag. Sci. 2017, 73, 896–903. [Google Scholar] [CrossRef] [PubMed]
- Van der Hoeven, E.P.; Bollen, G.J. Effect of benomyl on soil fungi associated with rye. 1. Effect on the incidence of sharp eyespot caused by Rhizoctonia cerealis. J. Plant Pathol. 1980, 86, 163–180. [Google Scholar] [CrossRef]
- Iwasa, T.; Higashide, E.; Shibata, M. Studies of validamycins, new antibiotics. 3. Bioassay methods for the determination of validamycin. J. Antibiot. 1971, 24, 114–118. [Google Scholar] [CrossRef]
- Wu, H.; Qu, S.; Lu, C.; Zheng, H.; Zhou, X.; Bai, L.; Deng, Z. Genomic and transcriptomic insights into the thermo-regulated biosynthesis of validamycin in Streptomyces hygroscopicus 5008. BMC Genom. 2012, 13, 337. [Google Scholar] [CrossRef]
- Zhang, Y.; Lu, J.; Wang, J.; Zhou, M.; Chen, C. Baseline sensitivity and resistance risk assessmemt of Rhizoctonia cerealis to thifluzamide, a succinate dehydrogenase inhibitor. Pestic. Biochem. Physiol. 2015, 124, 97–102. [Google Scholar] [CrossRef]
- Trinci, A.P.J. Effect of validamycin A andl-sorbose on the growth and morphology of Rhizoctonia cerealis and Rhizoctonia solani. Exp. Mycol. 1985, 9, 20–27. [Google Scholar] [CrossRef]
- Robson, G.D.; Kuhn, P.J.; Trinci, P.J. Antagonism by sugars of the effects of validamycin A on growth and morphology of Rhizoctonia cerealis. Mycol. Res. 1990, 95, 129–134. [Google Scholar] [CrossRef]
- Copping, L.G.; Menn, J.J. Biopesticides: A review of their action, applications and efficacy. Pest Manag. Sci. 2000, 56, 651–676. [Google Scholar] [CrossRef]
- Qian, K.; Shi, T.; Tang, T.; Zhang, S.; Liu, X.; Cao, Y. Preparation and characterization of nano-sized calcium carbonate as controlled release pesticide carrier for validamycin against Rhizoctonia solani. Microchim. Acta 2011, 173, 51–57. [Google Scholar] [CrossRef]
- Guirao Abad, J.; Sánchez-Fresneda, R.; Valentin, E.; Martinez-Esparza Alvargonzalez, M.; Argüelles, J.-C. Analysis of validamycin as a potential antifungal compound against Candida albicans. Int. Microbiol. 2013, 16, 217–225. [Google Scholar] [CrossRef] [PubMed]
- Matassini, C.; Parmeggiani, C.; Cardona, F. New frontiers on human safe insecticides and fungicides: An opinion on trehalase inhibitors. Molecules 2020, 25, 3013. [Google Scholar] [CrossRef] [PubMed]
- Lee, J.-H.; Saito, S.; Mori, H.; Nishimoto, M.; Okuyama, M.; Kim, D.; Wongchawalit, J.; Kimura, A.; Chiba, S. Molecular cloning of cDNA for trehalase from the european honeybee, Apis mellifera L., and its heterologous expression in Pichia pastoris. Biosci. Biotechnol. Biochem. 2007, 71, 2256–2265. [Google Scholar] [CrossRef] [PubMed]
- Li, J.; Duan, Y.; Bian, C.; Pan, X.; Yao, C.; Wang, J.; Zhou, M. Effects of validamycin in controlling fusarium head blight caused by Fusarium graminearum: Inhibition of DON biosynthesis and induction of host resistance. Pestic. Biochem. Physiol. 2019, 153, 152–160. [Google Scholar] [CrossRef] [PubMed]
- Bian, C.; Duan, Y.; Xiu, Q.; Wang, J.; Tao, X.; Zhou, M. Mechanism of validamycin A inhibiting DON biosynthesis and synergizing with DMI fungicides against Fusarium graminearum. Mol. Plant Pathol. 2021, 22, 769–785. [Google Scholar] [CrossRef]
- Bian, C.; Duan, Y.; Wang, J.; Xiu, Q.; Wang, J.; Hou, Y.; Song, X.; Zhou, M. Validamycin A induces broad-spectrum resistance involving salicylic acid and jasmonic acid/ethylene signaling pathways. Mol. Plant-Microbe. Interact. 2020, 33, 1424–1437. [Google Scholar] [CrossRef]
- Ren, L.; Hou, Y.P.; Zhu, Y.Y.; Zhao, F.F.; Duan, Y.B.; Wu, L.Y.; Duan, X.X.; Zhang, J.; Zhou, M.G. Validamycin A enhances the interaction between neutral trehalase and 14-3-3 protein Bmh1 in Fusarium graminearum. Phytopathology 2022, 112, 290–298. [Google Scholar] [CrossRef]
- Asano, N.; Yamaguchi, T.; Kameda, Y.; Matsui, K. Effect of validamycins on glycohydrolases of Rhizoctonia solani. J. Antibiot. 1987, 40, 526–532. [Google Scholar] [CrossRef] [PubMed]
- Lindsay, H. A colorimetric estimation of reducing sugars in potatoes with 3,5-dinitrosalicylic acid. Potato Res. 1973, 16, 176–179. [Google Scholar] [CrossRef]
- Zeng, Q.; Cao, W.; Li, W.; Wu, J.; Figueroa, M.; Liu, H.; Qin, G.; Wang, Q.; Yang, L.; Zhou, Y.D.; et al. Near telomere-to-telomere nuclear phased chromosomes of the dikaryotic wheat fungus Rhizoctonia cerealis. bioRxiv 2022. [Google Scholar] [CrossRef]
- Kumar, S.; Stecher, G.; Li, M.; Knyaz, C.; Tamura, K. MEGA X: Molecular Evolutionary Genetics Analysis across Computing Platforms. Mol. Biol. Evol. 2018, 35, 1547–1549. [Google Scholar] [CrossRef] [PubMed]
- Kim, D.; Paggi, J.M.; Park, C.; Bennett, C.; Salzberg, S.L. Graph-based genome alignment and genotyping with HISAT2 and HISAT-genotype. Nat. Biotechnol. 2019, 37, 907–915. [Google Scholar] [CrossRef] [PubMed]
- Pertea, M.; Pertea, G.M.; Antonescu, C.M.; Chang, T.C.; Mendell, J.T.; Salzberg, S.L. StringTie enables improved reconstruction of a transcriptome from RNA-seq reads. Nat. Biotechnol. 2015, 33, 290–295. [Google Scholar] [CrossRef] [PubMed]
- Love, M.I.; Huber, W.; Anders, S. Moderated estimation of fold change and dispersion for RNA-seq data with DESeq2. Genome Biol. 2014, 15, 550. [Google Scholar] [CrossRef] [PubMed]
- Bai, L.; Li, L.; Xu, H.; Minagawa, K.; Yu, Y.; Zhang, Y.; Zhou, X.; Floss, H.G.; Mahmud, T.; Deng, Z. Functional analysis of the validamycin biosynthetic gene cluster and engineered production of validoxylamine A. Chem. Biol. 2006, 13, 387–397. [Google Scholar] [CrossRef]
- Zhang, H.; Wang, M.Q.; Xie, Y.Q.; Xiang, M.; Li, P.; Li, Y.; Zhang, L. Gene cloning and expression analysis of trehalose-6-phosphate synthase, glycogen synthase and glycogen phosphorylase reveal the glycometabolism in the diapause process of Aphidius gifuensis. J. Asia-Pac. Entomol. 2020, 23, 641–645. [Google Scholar] [CrossRef]
- Yang, M.; Zhao, L.; Shen, Q.; Xie, G.; Wang, S.; Tang, B. Knockdown of two trehalose-6-phosphate synthases severely affects chitin metabolism gene expression in the brown planthopper Nilaparvata lugens. Pest Manag. Sci. 2017, 73, 206–216. [Google Scholar] [CrossRef]
- Cheng, J.; La Venuta, G.; Lau, B.; Berninghausen, O.; Beckmann, R.; Hurt, E. In vitro structural maturation of an early stage pre-40S particle coupled with U3 snoRNA release and central pseudoknot formation. Nucleic Acids Res. 2022, 50, 11916–11923. [Google Scholar] [CrossRef] [PubMed]
- Du, Y.; An, W.; Zhu, X.; Sun, Q.; Qi, J.; Ye, K. Cryo-EM structure of 90S small ribosomal subunit precursors in transition states. Science 2020, 369, 1477–1481. [Google Scholar] [CrossRef] [PubMed]
- Cheng, J.; Lau, B.; La Venuta, G.; Ameismeier, M.; Berninghausen, O.; Hurt, E.; Beckmann, R. 90S pre-ribosome transformation into the primordial 40S subunit. Science 2020, 369, 1470–1476. [Google Scholar] [CrossRef] [PubMed]
- Lau, B.; Cheng, J.; Flemming, D.; La Venuta, G.; Berninghausen, O.; Beckmann, R.; Hurt, E. Structure of the maturing 90S pre-ribosome in association with the RNA exosome. Mol. Cell 2021, 81, 293–303. [Google Scholar] [CrossRef] [PubMed]
- Magnet, S.; Blanchard, J.S. Molecular insights into aminoglycoside action and resistance. Chem. Rev. 2005, 105, 477–498. [Google Scholar] [CrossRef] [PubMed]
- Polikanov, Y.S.; Aleksashin, N.A.; Beckert, B.; Wilson, D.N. The mechanisms of action of ribosome-targeting peptide antibiotics. Front. Mol. Biosci. 2018, 5, 48. [Google Scholar] [CrossRef] [PubMed]
- Lebaron, S.; Segerstolpe, A.; French, S.L.; Dudnakova, T.; de Lima Alves, F.; Granneman, S.; Rappsilber, J.; Beyer, A.L.; Wieslander, L.; Tollervey, D. Rrp5 binding at multiple sites coordinates pre-rRNA processing and assembly. Mol. Cell 2013, 52, 707–719. [Google Scholar] [CrossRef] [PubMed]
- Young, C.L.; Karbstein, K. The roles of S1 RNA-binding domains in Rrp5's interactions with pre-rRNA. RNA 2011, 17, 512–521. [Google Scholar] [CrossRef]
- Yu, W.; Qiu, Z.; Gao, N.; Wang, L.; Cui, H.; Qian, Y.; Jiang, L.; Luo, J.; Yi, Z.; Lu, H.; et al. PAK1IP1, a ribosomal stress-induced nucleolar protein, regulates cell proliferation via the p53–MDM2 loop. Nucleic Acids Res. 2010, 39, 2234–2248. [Google Scholar] [CrossRef]
- Goldfeder, M.B.; Oliveira, C.C. Utp25p, a nucleolar Saccharomyces cerevisiae protein, interacts with U3 snoRNP subunits and affects processing of the 35S pre-rRNA. FEBS J. 2010, 277, 2838–2852. [Google Scholar] [CrossRef]
- Venema, J.; Vos, H.R.; Faber, A.W.; van Venrooij, W.J.; Raué, H.A. Yeast Rrp9p is an evolutionarily conserved U3 snoRNP protein essential for early pre-rRNA processing cleavages and requires box C for its association. RNA 2000, 6, 1660–1671. [Google Scholar] [CrossRef][Green Version]
- Hughes, J.M.; Ares, M., Jr. Depletion of U3 small nucleolar RNA inhibits cleavage in the 5′ external transcribed spacer of yeast pre-ribosomal RNA and impairs formation of 18S ribosomal RNA. EMBO J. 1991, 10, 4231–4239. [Google Scholar] [CrossRef]
- Schluenzen, F.; Takemoto, C.; Wilson, D.N.; Kaminishi, T.; Harms, J.M.; Hanawa-Suetsugu, K.; Szaflarski, W.; Kawazoe, M.; Shirouzu, M.; Nierhaus, K.H.; et al. The antibiotic kasugamycin mimics mRNA nucleotides to destabilize tRNA binding and inhibit canonical translation initiation. Nat. Struct. Mol. Biol. 2006, 13, 871–878. [Google Scholar] [CrossRef]
- Schneider-Poetsch, T.; Ju, J.; Eyler, D.E.; Dang, Y.; Bhat, S.; Merrick, W.C.; Green, R.; Shen, B.; Liu, J.O. Inhibition of eukaryotic translation elongation by cycloheximide and lactimidomycin. Nat. Chem. Biol. 2010, 6, 209–217. [Google Scholar] [CrossRef]
- Shen, L.; Su, Z.; Yang, K.; Wu, C.; Becker, T.; Bell-Pedersen, D.; Zhang, J.; Sachs, M.S. Structure of the translating Neurospora ribosome arrested by cycloheximide. Proc. Natl. Acad. Sci. USA 2021, 118, e2111862118. [Google Scholar] [CrossRef] [PubMed]

Disclaimer/Publisher’s Note: The statements, opinions and data contained in all publications are solely those of the individual author(s) and contributor(s) and not of MDPI and/or the editor(s). MDPI and/or the editor(s) disclaim responsibility for any injury to people or property resulting from any ideas, methods, instructions or products referred to in the content. |
© 2023 by the authors. Licensee MDPI, Basel, Switzerland. This article is an open access article distributed under the terms and conditions of the Creative Commons Attribution (CC BY) license (https://creativecommons.org/licenses/by/4.0/).
Share and Cite
Yang, X.; Shu, Y.; Cao, S.; Sun, H.; Zhang, X.; Zhang, A.; Li, Y.; Ma, D.; Chen, H.; Li, W. Trehalase Inhibitor Validamycin May Have Additional Mechanisms of Toxicology against Rhizoctonia cerealis. J. Fungi 2023, 9, 846. https://doi.org/10.3390/jof9080846
Yang X, Shu Y, Cao S, Sun H, Zhang X, Zhang A, Li Y, Ma D, Chen H, Li W. Trehalase Inhibitor Validamycin May Have Additional Mechanisms of Toxicology against Rhizoctonia cerealis. Journal of Fungi. 2023; 9(8):846. https://doi.org/10.3390/jof9080846
Chicago/Turabian StyleYang, Xiaoyue, Yan Shu, Shulin Cao, Haiyan Sun, Xin Zhang, Aixiang Zhang, Yan Li, Dongfang Ma, Huaigu Chen, and Wei Li. 2023. "Trehalase Inhibitor Validamycin May Have Additional Mechanisms of Toxicology against Rhizoctonia cerealis" Journal of Fungi 9, no. 8: 846. https://doi.org/10.3390/jof9080846
APA StyleYang, X., Shu, Y., Cao, S., Sun, H., Zhang, X., Zhang, A., Li, Y., Ma, D., Chen, H., & Li, W. (2023). Trehalase Inhibitor Validamycin May Have Additional Mechanisms of Toxicology against Rhizoctonia cerealis. Journal of Fungi, 9(8), 846. https://doi.org/10.3390/jof9080846

